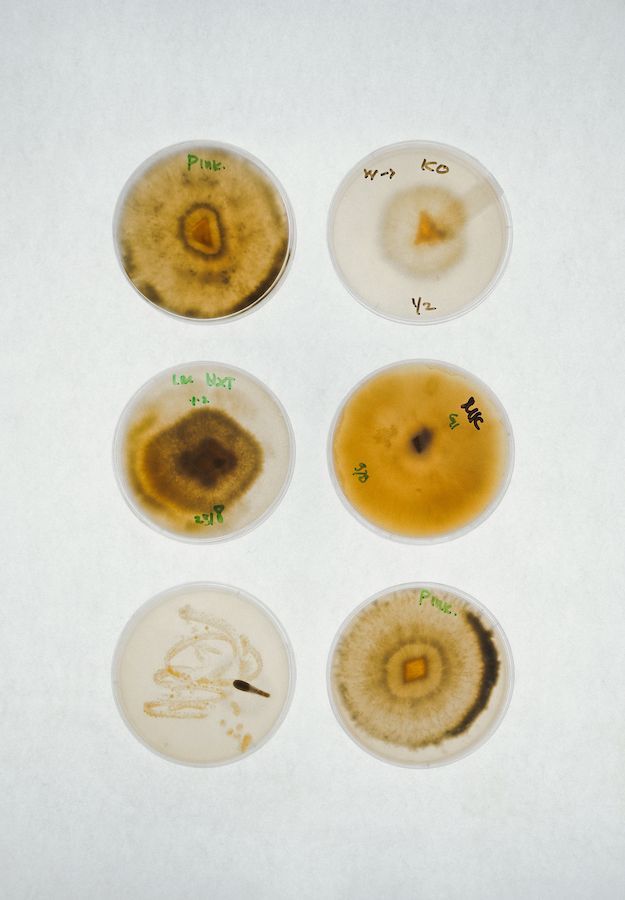
Locavore NXT

Photographed by Yohan Liliyani
Imagine taking a chef’s knife big enough to slice straight through the entire NXT project, splitting it open to reveal all its inner workings. One bold cut through the core, and suddenly, everything beneath the surface comes alive.
We’re taking you to see the heartbeat of Locavore NXT: the departments, the facilities and the people who make it all happen. So come with us as we dissect the space and take you ‘backstage’.

OK, so we’re not technically backstage yet, but while the Kitchen might get the spotlight, the Front of House team is the pulse you feel from the moment you walk through our edible-landscaped pathways. If the restaurant is a story, our FOH team are the narrators—a friendly smile setting the tone, taking care of our guests, turning the pages for you and making sure you understand the plot.

Daily napkin origami session


Our Restaurant Manager, Putri
Wooden coins used as a means of communication among the FOH, Kitchen and Beverage team during service
If we were to say that beverages play second fiddle to food in restaurants, sure you’d be right most of the time. The Beverage team at NXT might have a thing or two to say about that... and will casually slide you a glass filled with fermented fruits, mysterious infusions and perhaps a little dash of liquid wizardry.
Quietly keeping everything flowing, bubbling, fizzing and very much alive (we’re talking about the kombuchas), their job is to bottle up creativity whilst staying true to our local-ingredient-only philosophy. (Editor: Except wine. We love wine, but the good stuff, sadly for now, doesn’t grow around here.)

Getting everything in line before the service starts


A dash of this, a sprinkling of that…
Just a friendly microbial mat doing the slow work of transformation (aka SCOBY)
At the heart of NXT, behind our mysterious Balinese door and through clouds of steam, lives a sharply focused team with their innate skills, senses and instincts on full display. Helmed by the gentle yet firm forces of sous chefs Sook Yi and Karlina, the team's collaboration is like another living organism as they ride the rhythm of their kitchen.


Chef Ray leading the team during briefing
Service prep: the quiet rumble before the feast

Plating some edible geometry
If a dragon has its cave filled with chests of gold, the treasure chest at NXT is the Dry Storage, a.k.a. the pantry. It’s kept safe by the one and only Ajik Ose, who, for the record, is not a dragon. This is where everything arrives, is accounted for, stored and made ready to fuel the teams across the project. It’s a cross between the most beautiful and organised pantry you’ve ever seen, a farmers’ market, a forager’s basket, an arctic winterland (walk-in chillers) sparkling with frosted goods, a stationery shop (because we all need pens, don’t we?), and one of those fancy organic grocery stores in middle-class neighbourhoods (yes, Whole Foods, we’re talking about you).

Ajik Hose neatly keeping track of the supplies


Dry Storage isn’t just for dry goods – tucked between spices and toilet paper, some seriously good liquor that the Beverage team has produced
A peek (from the window) at the secret stash that keeps all departments stocked up
Now we’re at the Fermentation kitchen—it’s like NXT’s own digestive system, so to speak. Like a hidden belly working hard on a meal, fermentation takes simple ingredients and alchemises them into something truly potent. Forget the noise outside, the real transformation is happening in this dark digestive space. Take a look and witness the quiet power at work.


Filtering the funk
A close-up of our tempe, used in Nature’s Compass tasting menu

Solidly working together, like yeast and sugar


Fermentation team’s arsenal of flavour-making gadgets
The kenari camembert squad reporting for duty
Tucked away in their sterile, quiet corner of NXT, the Mushroom team is part farmer and part scientist. Every day, they suit up and step into their sanctuary—where not even a speck of dust dares to land and every spore is treated so preciously. In collaboration with Kulture Mushrooms, our underground Mushroom Chamber is home to a rotating cast of curious fungi—20 species strong and always growing (5 species at a time).


A typical day in the mushroom lab
Dissecting a mushroom

Little circles of potential
When the spores sprout!
Welcome to LabX. Here, someone’s always asking, “What if we tried this?” and follows it down a rabbit hole of edible experiments. If the rest of NXT is where dishes come to life, LabX is where they’re born. The team here doesn’t just follow recipes, they challenge them, break them and build something better from the crumbs. Step inside and explore the delicious playground of Locavore NXT.

From the outside, it’s all quiet reflection


The glass window knows things
LabX prep mode
Out in Bali’s blazing sun, with hands in the soil and sometimes elbow-deep in compost, you’ll find the Farm and Landscape team, quietly doing the not-so-quiet work of keeping things alive. They tend, trim, plant and pull with their relentless attitude. This team keeps the roots of NXT thriving—literally.


Side by side, seed by seed
Ari in her element

Inside our rooftop Joglo, where tiny seeds are nurtured


A florist in the wild
Inside the gardener's arsenal
When we built Locavore NXT, we decided that waste wouldn’t be an afterthought but rather its own ecosystem. And so... somewhere between the kitchen’s hustle and the garden’s green calm, there’s a less glamorous corner of NXT, where the leftovers go. With a small, diligent team headed by Sous Chef Sook Yi and the lovely Multitasker of NXT, Vita, the Circular Waste Centre is where our scraps get a second shot at life. The journey of implementing this system into NXT wasn’t always seamless, but what started as hard work for everyone now becomes natural and diverts over 98% of our waste from landfill. Take a peek…

Just another day at CWC


Feeding the Weedoo machine its daily dose of leftovers
Not all heroes wear aprons